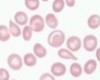

L7: Intro to Anaemia Flashcards
(43 cards)
Define anaemia
Anaemia is haemoglobin below the reference range for the normal population (reference range varies between areas)
State the signs & symptoms of anaemia
Symptoms
- Shortness of breath
- Tiredness
- Palpitations
- Headache
Signs
- Pallor
- Tachycardia
- Tachypnoea
- Hypotension
Alongside usual signs of anaemia, there are also some specific signs relating to the cause of the anaemia; state the specific signs for each of the following causes:
- Iron deficiency
- Vit B12 deficiency
- Thalassaemia
Iron deficiency
- Koilonychia (spoon nails/thin, concave, brittle fingernails)
- Oesophageal webs (Plummer Vinson Syndrome: thin mucosal membranes form across lumen of oesophagus leading to dysphagia)
- Angular stomatitis (inflammation in corners of mouth- red, itchy, painful, crusty)
Vit B12
- Glossitis (inflammation of tongue so it looks smooth)
Thalassaemia
- Abnormal fascial bone development

Describe the life cycle of a RBC

Define dyserythropoiesis
Defective erythropoiesis
Describe role of erythropoietin and the mechanism by which more is released
Erythropoietin stimulates the differentiation of the common myeloid progenitor cell into erythrocytes.
If interstitial peritubular cells in kidney dectect reduced PO2 then more erythropoietin will be produced by the kidneys. This stimulates production of more RBCs in red marrow to increase number of RBCs in blood therefore increasing Hb in blood and hence oxygen carrying capacity.

State three reasons why reduced erythropoiesis may occur
- Kidney stops making EPO e.g. in chronic kidney disease
- Empty bone marrow (no reticulocytes to stimulate or release)
- Marrow infiltrated by cancer cells or fibrous tissue (number of haemopoietic stem cells reduced)
Describe 3 things that occur in anaemia of chronic disease which leads to dyserythropoiesis
- Iron not released for use in bone marrow
- Reduced lifespan of RBCs
- Marrow shows lack of response to erythropoietin
What two levels in plasma would be raised in patient with anaemia of chronic disease?
- CRP
- Ferritin
State some conditions in which anaemia of chronic disease may be seen
- Renal disease
- Inflammatory diseases (rheumatoid arthritis, IBD)
- Chronic infections
Describe what myelodysplastic syndromes are and how they can lead to dyserythropoiesis
Primary haematological disorders in which there is production of abnormal clones of marrow stem cells due to mutations hence they are identified as normal and not released
Defects in haemoglobin synthesis can also result in anaemia by altering the structure of Hb or amount produced; state 3 reasons that defective Hb may be produced
- Lack of Fe (either due to deficiency or a functional lack of iron e.g. such as in anaemia of chronic disease) hence haem synthesis is reduced
- Lack of B12 or folate hence DNA synthesis impaired
- Mutations in the proteins that form globin chains (e.g. in sickle cell, thalassaemia)
Explain how defects in structure of RBC membrane can lead to anaemia
Defects can be inherited or acquired, provide examples for each
Defects may make RBCs less flexible hence they are damaged more easily; once they are damaged they are either broken down in ciruclation or removed by RES
- Inherited: hereditary spherocytosis, heriditary elliptocytosis
- Acquired: mechanical damage (e.g. heart valves, DIC, vasculitis), heat damage, osmotic damage
What does a high reticulocyte count indicate when investigating anaemia?
Kidneys and bone marrow are responding to decreased Hb and RBCs so erythropoiesis is fine. Must therefore investigate:
- Acute blood loss
- Splenic sequestration
- Haemolysis
Defects in RBC metabolism can also cause anaemia; state two enzymes in RBCs that may be affected and explain how defects in each would cause anaemia
- Glucose-6-phosphate dehydrogenase: is essential for producing NADPH. NADPH reduces GSSG back to GSH (the oxidised form) which provides protection against oxidative stress. Less NADPH, less protection against oxidative stress hence lipid peroxidation can occur (leading to cell membrane damage) and protein damage (leading to aggregates of cross-linked Hb= Heinz bodies); this will lead to increased haemolysis
- Pyruvate kinase: RBCs lack mitochondira hence glycolsysis is the only metabolic pathway by which they can supply ATP for cellular process; pyruvate kianse is enzyme for last step of glycolysis
Give some examples of how blood may be lost and therefore cause anaemia
- Trauma
- Haemorrhage
- Menstruation
State 6 generic ways in which anaemia may develop
- Reduced erythropoiesis
- Defects in Hb synthesis
- Defects in structure of RBC membranes
- Defects in RBC metabolism
- Loss of RBCs
- Excess removal of RBC by RES
How may excess removal of RBC by RES cause anaemia?
Spleen and other RES tissues remove damaged or defective RBCs; if removed more quickly than produced can cause anaemia. Destruction can occur intravascularly or extravascularly.
Explain the pathogenesis of autoimmune haemolytic anaemia
Autoantibodies bind to proteins on RBC membrane (these proteins are usually present/it is normal for them to be there); cells in RES recognise part of antibody and attach to it and remove it, and the RBC, from circulation. Decreases number of RBCs in circulation
Explain how myelofibrosis can cause anaemia
Bone marrow becomes fibrotic hence erythropoiesis is reduced as the fibrotic marrow reduces the space for haemopoietic stem cells in bone marrow. Due to reduced space for haemopoietic stem cells, RBCs are forced out of bone marrow causing them to have a teardrop shape; RES removes these as they are abnormal.
Explain why splenomegaly can occur is erythropoiesis is reduced in the bone marrow
Other sites, such as spleen, take on role of erythropoiesis “extramedullary haemopoeisis”
What does a high reticulocyte count indicate when investigating anaemia?
Kidneys and bone marrow not responding to decreased Hb and RBC. Hence we must investigate:
- Microcytic: thalassaemia, aneamia of chronic disease, lead poisoning, sideroblastic anaemia, iron deficiency
- Normocytic: primary bone marrow failure (e.g. aplastic anaemia) or secondary bone marrow failure (e.g. HIV, anaemia of chronic disease, endocrine abnormalities)
- Macrocytic: Vit b12 deficiency, folate deficiency, liver disease, hypothyroidism, alcoholism
Describe how vitamin B12 and/or folate deficiency can cause anaemia; state the typof anaemia it causes
Vit B12 & folate are essential for DNA synthesis hence a deficiency means that DNA synthesis doesn’t occur as it should so nuclear maturation and cell division lag behind cyotplasm development; results in large RBC precursors being released into blood stream. Known as megaloblastic anaemia (a type of macrocytic anaemia). RBC has large nucleus and open chromatin. It is the most common cause of macrocytic anaemia.
NOTE: if deficeincy is severe then neutropenia, & thrombocytopenia may also occur (hence pancytopenia)
Describe B12 absorption
- B12 binds to haptocorrin which is secreted by salivary glands
- B12-haptocorrin complex travels to stomach and then to small intestine
- In small intestine, B12 released from haptocorrin and binds to intrinsic factor (which is produced by parietal cells in stomach)
- IF-B12 complex binds to receptors on terminal ileum and the B12 is absorbed and the IF destroyed
- Once absorbed, B12 forms complex with transcobalamin II; complex released into blood for delivery to tissues
- Approximately half is taken up by liver for storage (3-6 years storage)